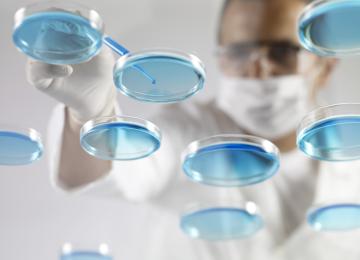

Iran’s Legal Medicine Organization (ILMO) reports that in the first month of the current calendar year that started in March, 6,928 people were injured in street altercations and brawls in the…
People
<p>Iran people news, Read the latest news on Iran's society, including developments in sciences, education, universities, and students, along with stories about Iran health sector. </p>
- People
Iran has adopted a pragmatic approach in fighting HIV/AIDS, and has successfully executed one of the most effective programs in this regard with the participation of civil society, said Gholamali…
PeopleScientists have found dangerous drug-resistant “super bacteria” off beaches in Rio de Janeiro that will host Olympic swimming events and in a lagoon where rowing and canoe athletes will compete…
PeopleThe ‘yellow rust’ pest was identified in Iran’s South Khorasan barberry gardens ten years ago for the first time. Since then, 670 hectares of the gardens have been destroyed due to the pest.
PeoplePresident of Vatican’s Pontifical Council for the Family, Archbishop Vincenzo Paglia, is in Iran to meet state officials and discuss matters relating to women and families.
PeopleAn Iranian researcher and associate professor in the Department of Chemistry at the University of Science and Technology in Tehran has been awarded the 2016 CHEMRAWN VII for Green Chemistry…
PeopleConscripts will not receive their military service cards if they are illiterate at the time of completing the compulsory military service, says the head of Iran’s Literacy Movement Organization.…
PeopleThe traffic police in Iran are ensuring that drivers are fined $9 for litter thrown from their vehicles – even if their passengers are to blame. “The law was passed earlier but has recently come…
PeopleThe ruins of Anahita Temple in Kangavar, Kermanshah Province will take years before its dossier can be reviewed for inscription on the World Heritage List, the historical site’s new director said…
PeopleDubai International Airport, the world’s busiest airport for international travel, closed its airspace for 69 minutes due to an unauthorized drone activity on Saturday, causing 22 flights to be…
PeopleSeventy percent of investors in Saudi Arabia’s tourism entertainment sector have pulled out and turned to other sectors.
Their action was blamed on frustrating bureaucratic procedures and…
PeopleIt is almost impossible for a tourism official to give a speech or an interview without mentioning that Iran’s inbound tourism numbers have increased by 12% in the past two years, which is three…
PeopleFlights between Bushehr in southwestern Iran and Dubai in the UAE, which were suspended last year, will recommence in the first week of the Iranian month of Tir (starting June 21) in cooperation…
PeoplePolice officers patrolling Sadeqieh Subway Station in western Tehran confiscated 30 relics worth an estimated 30 billion rials ($870,000) last week from a man who claimed to have brought them from…
PeopleThe Food and Agriculture Organization is promoting pesticide-free rice farming across 40 hectares of farmland in Azbaran village in Fereydunkenar, Mazandaran Province through monetary assistance…
PeopleThe labor minister’s advisor on women and family affairs has censured the “conservative approach” of the mass media when dealing with issues concerning women.
“Mass media have the task to…
PeopleResearch, published this week in ‘The BMJ’, unearths racial and sexual disparity in the paychecks of physicians. Even after controlling for a number of variables, the income gulf remained…
PeopleA compound found in green tea has shown promise for the treatment of Down syndrome, according to a new study published in The Lancet Neurology.
Study co-leader Dr. Mara Dierssen, of…
PeopleThe first Iftar charity festival in the fasting month of Ramadan was held June 9-11 at the Mafakher Museum, Arak, in Markazi Province. The festival’s proceeds will be used for the benefit of MS…
PeopleIn the first quarter of the current year that started on March 20, around 90 new surveillance cameras will be installed to monitor the free flow of traffic and register violations on major…
PeopleA ceremony was held at Tehran’s Nahjolbalaghe Park on Thursday on the eve of the World Day Against Child Labor marked on June 12 annually. It was organized by the non-governmental organization ‘…
PeopleOne Arizona Valley woman got an amazing gift for her 100th birthday: A great-great-grandson. Weston Alexander Heiser was born on Monday, June 6. That’s exactly 100 years to the day since Dorothy…
PeopleIran was able to supply 100% of its blood needs through voluntary donations in 2015, while 73 countries in the world achieved 90% success. “We continue to encourage people to donate blood and the…
PeopleMobile apps that share information about animal sightings have become “a major cause for concern”, according to the authority that runs national parks in South Africa.
Their use had led to…
PeopleThe Council of Ministers on Friday approved a roadmap containing a set of guidelines aimed at reducing air pollution in Iran’s eight metropolises and instructed relevant bodies with their duties…
People